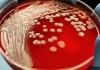
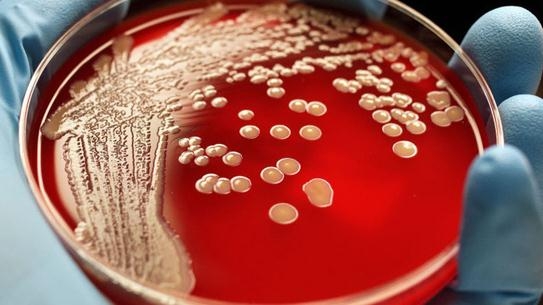

THÔNG TIN Y KHOA
Khi mỡ máu (Triglycerides) tăng dần
Có thể do tăng vài cân nên kết quả xét nghiệm triglycerides cũng có chiều hướng tăng. Những chất béo này là nguồn năng lượng quan trọng của cơ thể, tuy nhiên nồng độ cao sẽ gây tác hại cho tim. Cũng như cholesterol, triglycerides cao sẽ dẫn đến tắc nghẽn động mạch, có khả năng gây nhồi máu cơ tim hoặc đột quỵ. May mắn là bạn có nhiều biện pháp để giảm lượng triglycerides.
Xem thêm
Những Điều Cần Biết Ngay Về "Kháng Kháng Sinh"
Kháng kháng sinh ảnh hưởng trực tiếp đến bạn. Hãy nhớ lại xem, bạn từng phải dùng đến hai loại kháng sinh trong đơn thuốc hay điều trị bệnh đến hai đợt chưa? Sử dụng kháng sinh khi không cần thiết, ví dụ trong bệnh cảm cúm, sẽ khiến các vi khuẩn trong đường ruột của bạn mang gen kháng thuốc. Khi chúng có điều kiện thuận lợi để phát bệnh, bạn sẽ biết thế nào là hậu quả.
Xem thêm
Điều Trị Bệnh Ung Thư: Khoa Học Và Dân Gian
Gần đây, có một số tin tức mới về việc điều trị bệnh ung thư được cho là nguồn từ Bệnh viện Johns Hopkins, một bệnh viện lớn có uy tín khá cao ở Mỹ được khá nhiều người theo dõi và tin tưởng. Bản tin cung cấp khá nhiều thông tin mang tính khoa học và khá chính xác nhưng đồng thời cũng kèm với khá nhiều thông tin đi ngược với các điều trị kinh điển của y khoa. Đâu là sự thực và người bệnh có thể làm gì để tự cứu mình?
Xem thêm
Khàn tiếng không chị gây bất tiện hay khó chịu trong cuộc sống của một số người, khan tiếng còn là dấu hiệu của một số bệnh lý, trong đó có những bệnh nguy hiểm như lao dây thanh, ung thư,… Nếu bị khàn tiếng bạn nên tìm hiểu rõ nguyên nhân và chữa trị.
Xem thêm
Viêm khớp vảy nến là gì?
Vảy nến là tình trạng trên da xuất hiện các mảng dày, màu đỏ, trắng hoặc màu bạc và ngứa. Khi bị vảy nến, người bệnh có khả năng bị viêm khớp vảy nến. Tình trạng viêm da này nguyên nhân là do hệ miễn dịch có vấn đề. Hệ miễn dịch có thể tấn công các khớp gây sưng nề và cứng. Nếu được chẩn đoán sớm có khả năng giảm được thương tổn.
Xem thêm